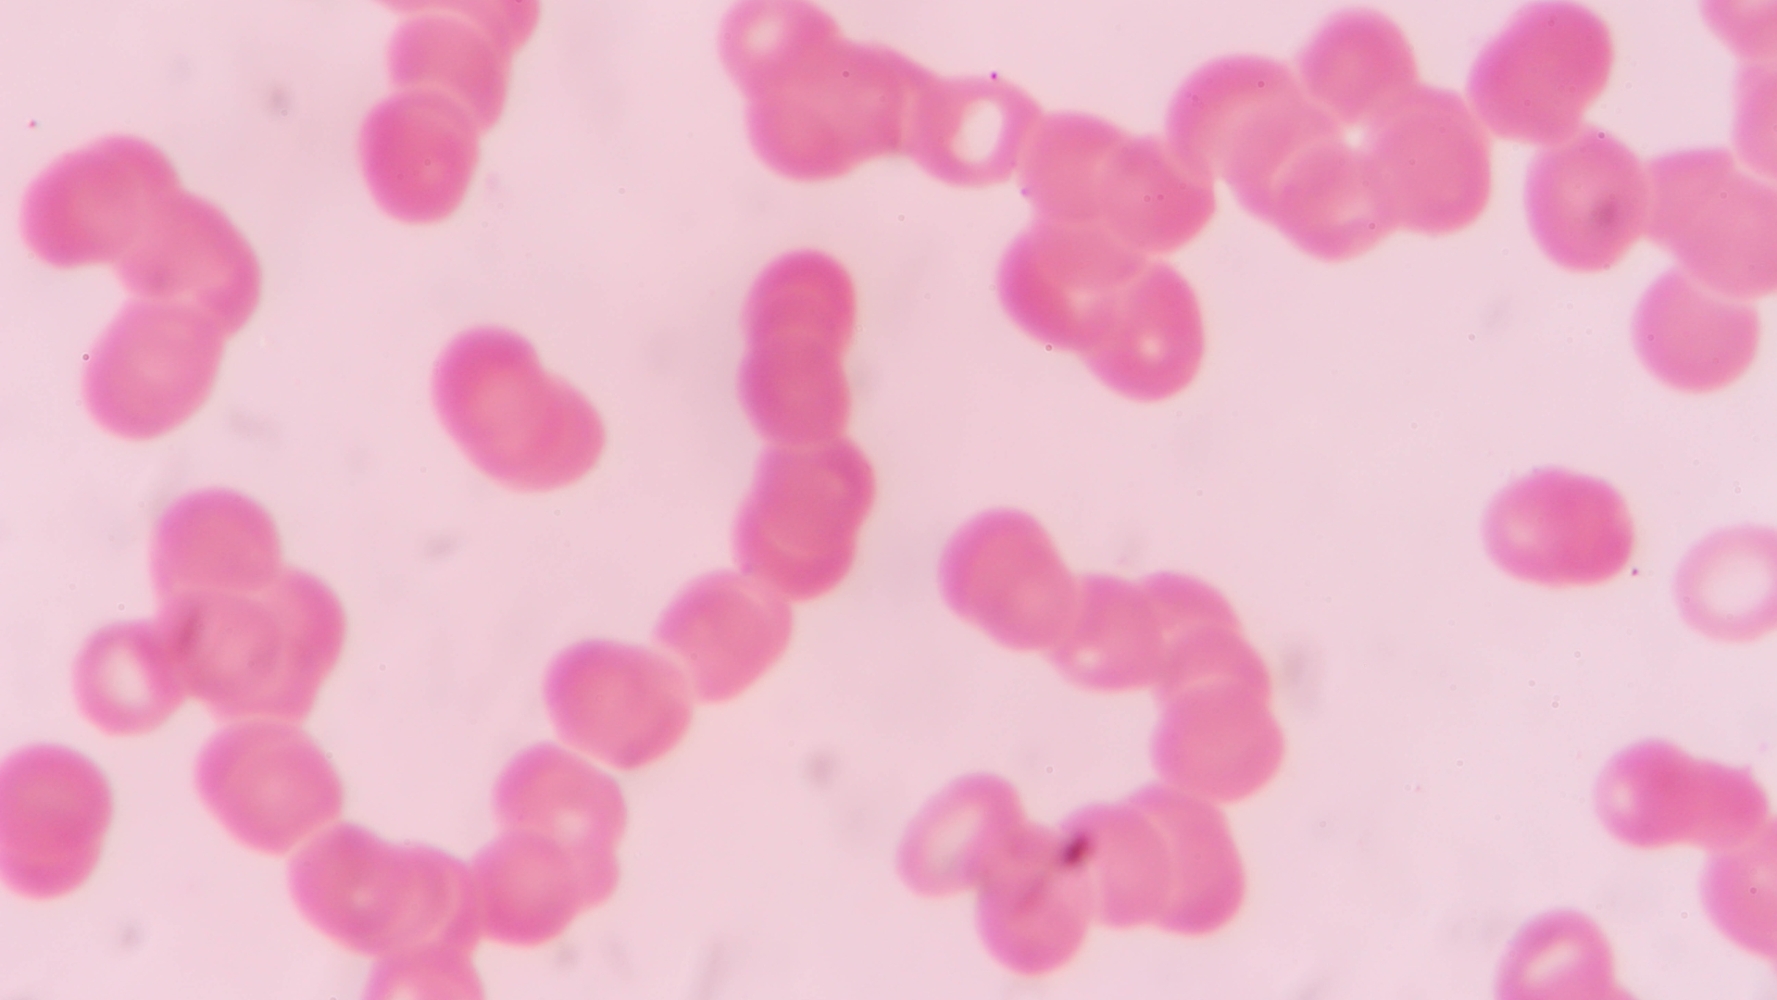

Case Review: Rouleaux Formation
History & Diagnosis
A 60-year-old male presented to our center after finding Rouleaux formation via dark field microscopy. Rouleaux formation (RF) is an abnormal process where red blood cells are visualized with a stacked coin-like appearance. This stacking and increased sedimentation of red blood cells can typically be caused by increased plasma proteins such as immunoglobulins and/or fibrinogen. Other common causes of RF include but are not limited to poor or decreased blood flow, chronic infection, and significant inflammatory processes. This patient reported very low energy levels, chronic headaches, and body pains. He shared that he felt healthy for most of his life until about 5 years before his initial visit. During this time, while his health declined, he experimented with different types of ozone therapies before developing a hypersensitivity reaction to them. Feeling like he had exhausted all of the options that were available to him, he sought evaluation at our center in hopes of finding the root cause of his condition and exploring new treatment options.
Evaluation
A comprehensive analysis of the patient revealed the following:
- Very high tissue toxicity – 18 on Dr. Schimmel’s scale
- Dr. Schimmel’s scale involves a toxicity score ranging from 0-21. As a reference, a normal range for a healthy individual is considered 1-8.
- Significant heavy metal toxicity, including aluminum, resulting in disturbance of autonomic nervous system function
- Multiple nutritional deficiencies, including vitamins D/E and minerals (magnesium, selenium, and zinc)
- Multiple pathogens, including EBV, Borrelia, Bartonella, Aspergillus, Babesia, and intestinal flukes
- Foci or disturbance fields in his pelvic region caused by a localized chronic inflammatory process and further disruption of his autonomic nervous system
Each patient is extremely unique. While we often find similar issues such as high toxicity, chronic infection, inflammatory processes, etc., the way these imbalances manifest in a patient’s symptomatology is quite diverse.
-Nicole Ritieni, NP, Clinical Director
Learn more about our healing approach. Sign up below.
Treatment
A personalized program of treatment was established to reduce the toxic burden, address infections and heavy metal toxicity, decrease chronic inflammation, and improve overall terrain. He started his treatment by cleansing his body and restoring the proper function of the organs and overall system using both oral and intravenous methods.
He took daily ionized minerals, nutritional supplements, and homeopathic preparations at home to open his drainage pathways and initiate detoxification. He also started rebuilding his milieu with Sanum and Symbiopathic preparations and detoxifying heavy metals with oral chelating agents.
A total of ten intravenous infusions were combined with oxidative therapies, neural therapy, and intramuscular antiviral injections using natural compounds. During his first week of intravenous therapy, energy balancing was performed using the French ACMOS Method, an advanced therapeutic system similar to acupuncture but without needles. After his first phase of treatment with detoxification, the patient repeated his dark field microscopy analysis, which revealed a 90% resolution of his Rouleaux formation. This patient was trained in dark field microscopy technique and continued to reassess his patterns between treatment phases.
Following detoxification, his BAH indicated four sessions of antimicrobial therapies administered weekly. Once the infection was successfully eradicated, the patient moved on to his final phase of treatment with regenerative therapies. This included an NAD+ IV and PK Protocol to improve mitochondrial function, promote intracellular detoxification, and strengthen the integrity of cell structure.
Results
The patient reported feeling a significant improvement in energy levels and headaches. By this time, he visualized his red blood cells’ 100% normal-appearing formation using dark field microscopy. Following his final treatments at our clinic, his BAH evaluation showed the eradication of all infections detected on his initial evaluation, significant improvement in heavy metal toxicity, and a large resolution of his chronic inflammation.
Although the patient had a positive outcome, proper follow-up is required to ensure the prolonged success of his treatment. His initial follow-up four weeks after his first treatment program reflected good results, and the patient was still feeling well. A few months later, the patient reported an increase in some of his symptoms and was re-evaluated. This patient experiences occupational toxin exposure to heavy metals and requires more support. A recurrence of heavy metal toxicity began to increase inflammation, and the Rouleaux formation reappeared. BAH re-evaluation revealed the patient required slightly more detoxification and IV Chelation with Calcium EDTA.
This patient continues to comply with follow-ups as indicated. In doing so, he ensures that he’s taking proper precautions to prevent re-exposure to toxins and will assess the need for further intervention before a significant health problem manifests. Healing is a dynamic and ongoing process best supported by ongoing attention and assessment of one’s state of health.
Are You or a Loved One Suffering from Rouleaux Formation or Complex Chronic Illness?
Take our assessment and schedule a complimentary 20-minute consultation to learn how our personalized, comprehensive approach can transform your health. Take the first step toward healing, and contact us today.
Disclaimer: The statements made in this article have not been evaluated by the Food and Drug Administration. Any products or treatments mentioned are not intended to diagnose, treat, cure, or prevent any disease. Please consult a licensed medical practitioner for medical advice.
At Innovative Medicine, we believe in transparency. We want you to know that we may participate in affiliate advertising programs pertaining to products mentioned herein.
See how we can help you restore complete health of body, mind & spirit.
Join our mailing list and receive exclusive offers + information!